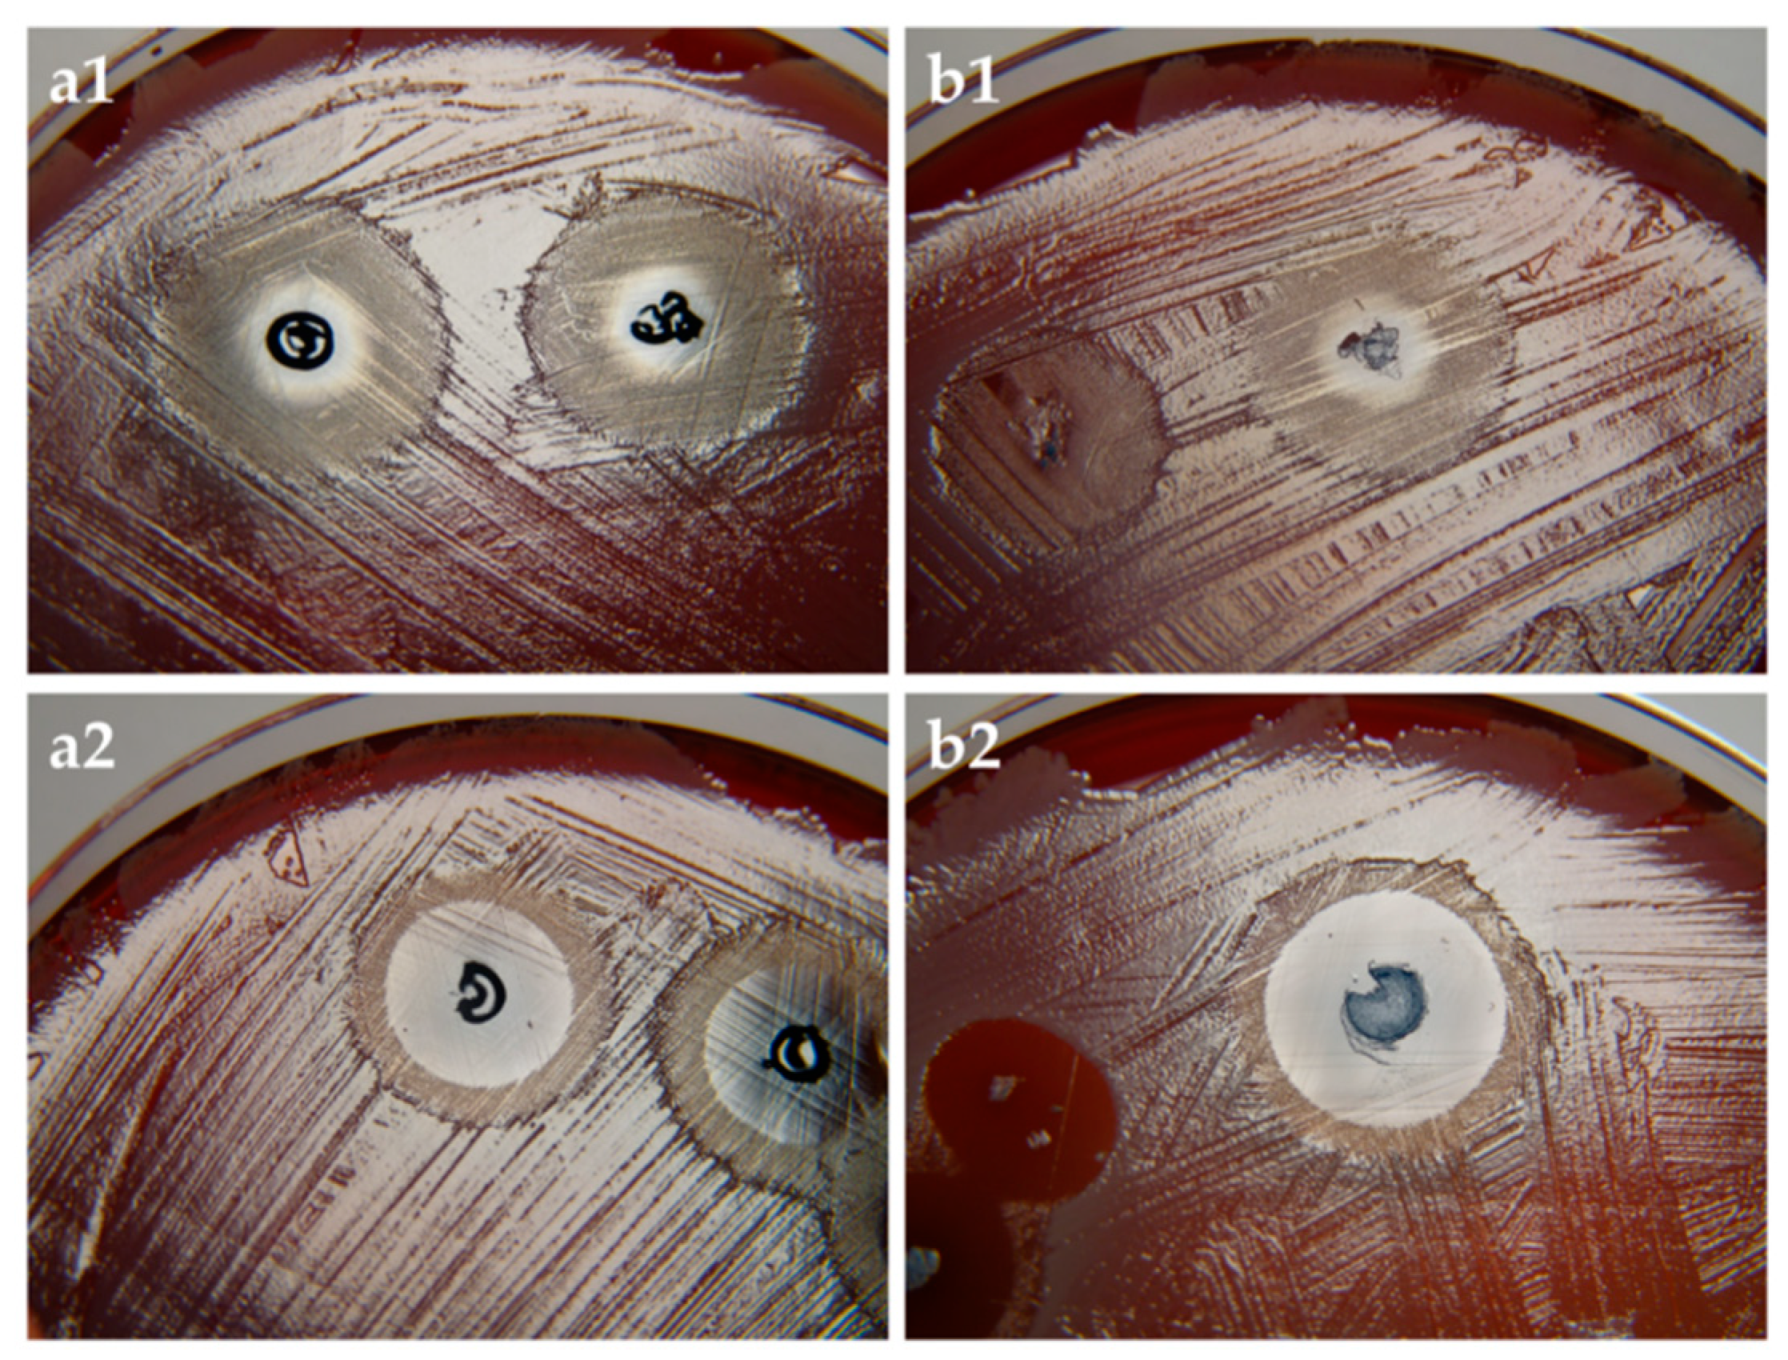
Pharmaceutics 11 00307 g006

The Use of Artificial Gel Forming Bolalipids as Novel Formulations in Antimicrobial and Antifungal Therapy
Abstract
1. Introduction
2. Materials and Methods
2.1. Materials
2.2. Preparation of Hydrogels and Aerogels
2.3. Characterization
2.3.1. Rheological Characterization of Hydrogels and Rehydrated Aerogels
2.3.2. Scanning Electron Microscopy (SEM) of Aerogels
2.4. Release Studies
2.5. Microbiology
2.5.1. Antifungal Activity of PC-C32-PC and Me2PE-C32-Me2PE Hydro- or Aerogels
2.5.2. Antifungal Activity of Loaded PC-C32-PC and Me2PE-C32-Me2PE Aerogels by Means of PDT
2.5.3. Antibacterial Activity of Loaded PC-C32-PC and Me2PE-C32-Me2PE Aerogels by Means of aPDT
2.6. Biocompatibility
2.6.1. Henn´s Egg Test on the Chorioallantoic Membrane (HET-CAM) of Hydrogels
2.6.2. Modified HET-CAM Assay with Bolalipid Aerogels
3. Results and Discussion
3.1. Characterization of Hydrogels and Aerogels
3.2. Release Studies
3.3. Microbiology
3.3.1. Antifungal Activity of PC-C32-PC and Me2PE-C32-Me2PE Hydro- or Aerogels
3.3.2. Antifungal Activity of Loaded PC-C32-PC and Me2PE-C32-Me2PE Aerogels by Means of PDT
3.3.3. aPDT with PC-C32-PC and Me2PE-C32-Me2PE Aerogels Containing Methylene Blue
3.4. Biocompatibility
3.4.1. HET-CAM of Bolalipid Hydrogels
3.4.2. HET-CAM of Bolalipid Aerogels
4. Conclusions
Supplementary Materials
Author Contributions
Funding
Acknowledgments
Conflicts of Interest
References
- World Health Organization. Antimicrobial Resistance: Global Report on Surveillance; World Health Organization: Geneva, Switzerland, 2014. [Google Scholar]
- Maisch, T.; Szeimies, R.M.; Jori, G.; Abels, C. Antibacterial photodynamic therapy in dermatology. Photochem. Photobiol. Sci. 2004, 10, 907–917. [Google Scholar] [CrossRef] [PubMed]
- Dai, T.; Huang, Y.Y.; Hamblin, M.R. Photodynamic therapy for localized infections—State of the art. Photodiagn. Photodyn. Ther. 2009, 6, 170–188. [Google Scholar] [CrossRef] [PubMed]
- Wainwright, M.; Phoenix, D.A.; Laycock, S.L.; Wareing, D.R.A.; Wright, P.A. Photobactericidal activity of phenothiazinium dyes against methicillin-resistant strains of Staphylococcus aureus. FEMS Microbiol. Lett. 1998, 160, 177–181. [Google Scholar] [CrossRef] [PubMed]
- Calzavara-Pinton, P.G.; Venturini, M.; Sala, R. A comprehensive overview of photodynamic therapy in the treatment of superficial fungal infections of the skin. J. Photochem. Photobiol. B Biol. 2005, 78, 1–6. [Google Scholar] [CrossRef] [PubMed]
- Baltazar, L.M.; Ray, A.; Santos, D.A.; Cisalpino, P.S.; Friedman, A.J.; Nosanchuk, J.D. Antimicrobial photodynamic therapy: An effective alternative approach to control fungal infections. Front. Microbiol. 2015, 6, 202. [Google Scholar] [CrossRef] [PubMed]
- Akilov, O.E.; Kosaka, S.; O’Riordan, K.; Hasan, T. Photodynamic therapy for cutaneous leishmaniasis: The effectiveness of topical phenothiaziniums in parasite eradication and Th1 immune response stimulation. Photochem. Photobiol. Sci. 2007, 6, 1067–1075. [Google Scholar] [CrossRef]
- Lin, C.C.; Metters, A.T. controlled release formulations: Network design and mathematical modeling. Adv. Drug Deliv. Rev. 2006, 58, 1379–1408. [Google Scholar] [CrossRef]
- Caló, E.; Khutoryanskiy, V.V. Biomedical applications of hydrogels: A review of patents and commercial products. Eur. Polym. J. 2015, 65, 252–267. [Google Scholar] [CrossRef]
- Boateng, J.S.; Matthews, K.H.; Stevens, H.N.; Eccleston, G.M. Wound healing dressings and drug delivery systems: A review. J. Pharm. Sci. 2008, 97, 2892–2923. [Google Scholar] [CrossRef]
- Ullah, F.; Othman, M.B.H.; Javed, F.; Ahmad, Z.; Akil, H.M. Classification, processing and application of hydrogels: A review. Mater. Sci. Eng. C 2015, 57, 414–433. [Google Scholar] [CrossRef]
- Peppas, N.A.; Bures, P.; Leobandung, W.; Ichikawa, H. Hydrogels in pharmaceutical formulations. Eur. J. Pharm. Biopharm. 2000, 50, 27–46. [Google Scholar] [CrossRef]
- Bhattacharya, S.; Acharya, S.G. Impressive gelation in organic solvents by synthetic, low molecular mass, self-organizing urethane amides of L-phenylalanine. Chem. Mater. 1999, 11, 3121–3132. [Google Scholar] [CrossRef]
- Fuhrhop, J.H.; Wang, T. Bolaamphiphiles. Chem. Rev. 2004, 104, 2901–2938. [Google Scholar] [CrossRef] [PubMed]
- Nuraje, N.; Bai, H.; Su, K. Bolaamphiphilic molecules: Assembly and applications. Prog. Polym. Sci. 2013, 38, 302–343. [Google Scholar] [CrossRef]
- Graf, G.; Drescher, S.; Meister, A.; Garamus, V.M.; Dobner, B.; Blume, A. Tuning the aggregation behaviour of single-chain bolaamphiphiles in aqueous suspension by changes in headgroup asymmetry. Soft Matter 2013, 9, 9562–9571. [Google Scholar] [CrossRef] [PubMed]
- Drescher, S.; Lechner, B.D.; Garamus, V.M.; Almásy, L.; Meister, A.; Blume, A. The headgroup (a) symmetry strongly determines the aggregation behavior of single-chain phenylene-modified bolalipids and their miscibility with classical phospholipids. Langmuir 2014, 30, 9273–9284. [Google Scholar] [CrossRef] [PubMed]
- Markowski, T.; Drescher, S.; Förster, G.; Lechner, B.D.; Meister, A.; Blume, A.; Dobner, B. Highly asymmetrical glycerol diether bolalipids: Synthesis and temperature-dependent aggregation behavior. Langmuir 2015, 31, 10683–10692. [Google Scholar] [CrossRef] [PubMed]
- Gulik, A.; Luzzati, V.; De Rosa, M.; Gambacorta, A. Structure and polymorphism of bipolar isopranyl ether lipids from archaebacteria. J. Mol. Biol. 1985, 182, 131–149. [Google Scholar] [CrossRef]
- Woese, C.R. Bacterial evolution. Microbiol. Rev. 1987, 51, 221. [Google Scholar]
- Mahmoud, G.; Jedelská, J.; Strehlow, B.; Bakowsky, U. ether lipids derived from thermoacidophilic archaeon Sulfolobus acidocaldarius for membrane stabilization of chlorin e6 based liposomes for photodynamic therapy. Eur. J. Pharm. Biopharm. 2015, 95, 88–98. [Google Scholar] [CrossRef]
- Engelhardt, K.H.; Pinnapireddy, S.R.; Baghdan, E.; Jedelská, J.; Bakowsky, U. Transfection studies with colloidal systems containing highly purified bipolar tetraether lipids from Sulfolobus acidocaldarius. Archaea 2017, 2017, 12. [Google Scholar] [CrossRef] [PubMed]
- Mahmoud, G.; Jedelská, J.; Strehlow, B.; Omar, S.; Schneider, M.; Bakowsky, U. Photo-responsive tetraether lipids based vesicles for prophyrin mediated vascular targeting and direct phototherapy. Colloids Surf. B Biointerfaces 2017, 159, 720–728. [Google Scholar] [CrossRef] [PubMed]
- Plenagl, N.; Duse, L.; Seitz, B.S.; Goergen, N.; Pinnapireddy, S.R.; Jedelska, J.; Brüßler, J.; Bakowsky, U. Photodynamic therapy–hypericin tetraether liposome conjugates and their antitumor and antiangiogenic activity. Drug Deliv. 2019, 26, 23–33. [Google Scholar] [CrossRef] [PubMed]
- Plenagl, N.; Seitz, B.S.; Reddy Pinnapireddy, S.; Jedelská, J.; Brüßler, J.; Bakowsky, U. Hypericin loaded liposomes for anti-microbial photodynamic therapy of gram-positive bacteria. Phys. Status Solidi A 2018, 215, 1700837. [Google Scholar] [CrossRef]
- Jacquemet, A.; Barbeau, J.; Lemiègre, L.; Benvegnu, T. Archaeal tetraether bipolar lipids: Structures, functions and applications. Biochimie 2009, 91, 711–717. [Google Scholar] [CrossRef] [PubMed]
- De Rosa, M.; Gambacorta, A. The lipids of archaebacteria. Progr. Lipid Res. 1988, 27, 153–175. [Google Scholar] [CrossRef]
- Köhler, K.; Förster, G.; Hauser, A.; Dobner, B.; Heiser, U.F.; Ziethe, F.; Blume, A. Self-assembly in a bipolar phosphocholine–water system: The formation of nanofibers and hydrogels. Angewandte Chem. Int. Ed. 2004, 43, 245–247. [Google Scholar] [CrossRef]
- Köhler, K.; Förster, G.; Hauser, A.; Dobner, B.; Heiser, U.F.; Ziethe, F.; Richter, W.; Steiniger, F.; Drechsler, M.; Stettin, H.; et al. Temperature-dependent behavior of a symmetric long-chain bolaamphiphile with phosphocholine headgroups in water: From hydrogel to nanoparticles. J. Am. Chem. Soc. 2004, 126, 16804–16813. [Google Scholar] [CrossRef]
- Köhler, K.; Meister, A.; Förster, G.; Dobner, B.; Drescher, S.; Ziethe, F.; Richter, W.; Steiniger, F.; Drechsler, M.; Hause, G.; et al. Conformational and thermal behavior of a pH-sensitive bolaform hydrogelator. Soft Matter 2006, 2, 77–86. [Google Scholar] [CrossRef]
- Graf, G.; Drescher, S.; Meister, A.; Dobner, B.; Blume, A. Self-assembled bolaamphiphile fibers have intermediate properties between crystalline nanofibers and wormlike micelles: Formation of viscoelastic hydrogels switchable by changes in pH and salinity. J. Phys. Chem. B 2011, 115, 10478–10487. [Google Scholar] [CrossRef]
- Meister, A.; Bastrop, M.; Koschoreck, S.; Garamus, V.M.; Sinemus, T.; Hempel, G.; Drescher, S.; Dobner, B.; Richtering, W.; Huber, K.; et al. Structure-property relationship in stimulus-responsive bolaamphiphile hydrogels. Langmuir 2007, 23, 7715–7723. [Google Scholar] [CrossRef]
- Tatsuta, M.; Okuda, S.; Tamura, H.; Taniguchi, H. Endoscopic diagnosis of early gastric cancer by the endoscopic congo red-methylene blue test. Cancer 1982, 50, 2956–2960. [Google Scholar] [CrossRef]
- Wainwright, M.; Crossley, K.B. Methylene blue-a therapeutic dye for all seasons? J. Chemother. 2002, 14, 431–443. [Google Scholar] [CrossRef] [PubMed]
- Tardivo, J.P.; Del Giglio, A.; de Oliveira, C.S.; Gabrielli, D.S.; Junqueira, H.C.; Tada, D.B.; Severino, D.; Baptista, M.S. Methylene blue in photodynamic therapy: From basic mechanisms to clinical applications. Photodiagn. Photodyn. Ther. 2005, 2, 175–191. [Google Scholar] [CrossRef]
- Koch, W.H.; Bass, G.E. Sodium azide affects methylene blue concentration in Salmonella typhimurium and Saccharomyces cerevisiae. Photochem. Photobiol. 1984, 39, 841–845. [Google Scholar] [CrossRef] [PubMed]
- Balouiri, M.; Sadiki, M.; Ibnsouda, S.K. Methods for in vitro evaluating antimicrobial activity: A review. J. Pharm. Anal. 2016, 6, 71–79. [Google Scholar] [CrossRef]
- Arikan, S.; Paetznick, V.; Rex, J.H. Comparative evaluation of disk diffusion with microdilution assay in susceptibility testing of caspofungin against Aspergillus and Fusarium isolates. Antimicrob. Agents Chemother. 2002, 46, 3084–3087. [Google Scholar] [CrossRef]
- Ribatti, D.; Nico, B.; Vacca, A.; Roncali, L.; Burri, P.H.; Djonov, V. Chorioallantoic membrane capillary bed: A useful target for studying angiogenesis and anti-angiogenesis in vivo. Anat. Rec. An Off. Publ. Am. Assoc. Anat. 2001, 264, 317–324. [Google Scholar] [CrossRef]
- Drescher, S.; Meister, A.; Blume, A.; Karlsson, G.; Almgren, M.; Dobner, B. General synthesis and aggregation behaviour of a series of single-chain 1, ω-Bis (phosphocholines). Chem. A Eur. J. 2007, 13, 5300–5307. [Google Scholar] [CrossRef]
- Meister, A.; Drescher, S.; Garamus, V.M.; Karlsson, G.; Graf, G.; Dobner, B.; Blume, A. Temperature-dependent self-assembly and mixing behavior of symmetrical single-chain bolaamphiphiles. Langmuir 2008, 24, 6238–6246. [Google Scholar] [CrossRef]
- Vögeling, H.; Duse, L.; Seitz, B.S.; Plenagl, N.; Wojcik, M.; Pinnapireddy, S.R.; Bakowsky, U. Multilayer bacteriostatic coating for surface modified titanium implants. Phys. Stat. Solidi A 2018, 215, 1700844. [Google Scholar] [CrossRef]
- Pinnapireddy, S.R.; Duse, L.; Strehlow, B.; Schäfer, J.; Bakowsky, U. Composite liposome-PEI/nucleic acid lipopolyplexes for safe and efficient gene delivery and gene knockdown. Colloids Surf. B Biointerfaces 2017, 158, 93–101. [Google Scholar] [CrossRef] [PubMed]
- Chanmugam, A.; Langemo, D.; Thomason, K.; Haan, J.; Altenburger, E.A.; Tippett, A.; Zortman, T.A. Relative temperature maximum in wound infection and inflammation as compared with a control subject using long-wave infrared thermography. Adv. Skin Wound Care 2017, 30, 406–414. [Google Scholar] [CrossRef] [PubMed]
- Duse, L.; Pinnapireddy, S.R.; Strehlow, B.; Jedelská, J.; Bakowsky, U. Low level LED photodynamic therapy using curcumin loaded tetraether liposomes. Eur. J. Pharm. Biopharm. 2018, 126, 233–241. [Google Scholar] [CrossRef] [PubMed]
- Tariq, I.; Pinnapireddy, S.R.; Duse, L.; Ali, M.Y.; Ali, S.; Amin, M.U.; Goergen, N.; Jedelská, J.; Bakowsky, U. Lipodendriplexes: A promising nanocarrier for enhanced gene delivery with minimal cytotoxicity. Eur. J. Pharm. Biopharm. 2019, 135, 72–82. [Google Scholar] [CrossRef] [PubMed]
- Lüring, C.; Kalteis, T.; Wild, K.; Perlick, L.U.; Grifka, J. Gewebetoxizität lokaler Anästhetika im HET-CAM-Test. Der Schmerz 2003, 17, 185–190. [Google Scholar] [PubMed]
- Hobzova, R.; Hampejsova, Z.; Cerna, T.; Hrabeta, J.; Venclikova, K.; Jedelska, J.; Bakowsky, U.; Bosakova, Z.; Lhotka, M.; Vaculin, S.; et al. Poly (d, l-lactide)/polyethylene glycol micro/nanofiber mats as paclitaxel-eluting carriers: Preparation and characterization of fibers, in vitro drug release, antiangiogenic activity and tumor recurrence prevention. Mater. Sci. Eng. C 2019, 98, 982–993. [Google Scholar] [CrossRef] [PubMed]
- Ribatti, D.; Nico, B.; Vacca, A.; Presta, M. The gelatin sponge–chorioallantoic membrane assay. Nat. Protoc. 2006, 1, 85. [Google Scholar] [CrossRef]
- Blume, A.; Drescher, S.; Meister, A.; Graf, G.; Dobner, B. Tuning the aggregation behaviour of single-chain bolaphospholipids in aqueous suspension: From nanoparticles to nanofibres to lamellar phases. Faraday Discuss. 2013, 161, 193–213. [Google Scholar] [CrossRef]
- Dash, S.; Murthy, P.N.; Nath, L.; Chowdhury, P. Kinetic modeling on drug release from controlled drug delivery systems. Acta Pol. Pharm 2010, 67, 217–223. [Google Scholar]
- Langer, R.; Peppas, N. Chemical and physical structure of polymers as carriers for controlled release of bioactive agents: A review. J. Macromol. Sci. Rev. Macromol. Chem. Phys. 1983, 23, 61–126. [Google Scholar] [CrossRef]
- Amsden, B. Solute diffusion within hydrogels. Mechanisms and models. Macromolecules 1998, 31, 8382–8395. [Google Scholar] [CrossRef]
- Aspiroz, C.; Sevil, M.; Toyas, C.; Gilaberte, Y. Photodynamic therapy with methylene blue for skin ulcers infected with Pseudomonas aeruginosa and Fusarium spp. Actas Dermo Sifiliogr. 2017, 108, e45–e48. [Google Scholar] [CrossRef] [PubMed]
- Schick, E.; Riick, A.; Boehncke, W.H.; Kaufmann, R. Topical photodynamic therapy using methylene blue and 5-aminolaevulinic acid in psoriasis. J. Derm. Treat. 1997, 8, 17–19. [Google Scholar] [CrossRef]
- Meister, A.; Drescher, S.; Mey, I.; Wahab, M.; Graf, G.; Garamus, V.M.; Blume, A. Helical nanofibers of self-assembled bipolar phospholipids as template for gold nanoparticles. J. Phys. Chem. B 2008, 112, 4506–4511. [Google Scholar] [CrossRef]
- Blume, A.; Drescher, S.; Graf, G.; Koehler, K.; Meister, A. Self-assembly of different single-chain bolaphospholipids and their miscibility with phospholipids or classical amphiphiles. Adv. Colloid Interface Sci. 2014, 208, 264–278. [Google Scholar] [CrossRef] [PubMed]
- Meister, A.; Köhler, K.; Drescher, S.; Dobner, B.; Karlsson, G.; Edwards, K.; Blume, A. Mixing behaviour of a symmetrical single-chain bolaamphiphile with phospholipids. Soft Matter 2007, 3, 1025–1031. [Google Scholar] [CrossRef]
- Kordts, M.; Kerth, A.; Drescher, S.; Ott, M.; Blume, A. The cmc-value of a bolalipid with two phosphocholine headgroups and a C24 alkyl chain: Unusual binding properties of fluorescence probes to bolalipid aggregates. J. Colloid Interface Sci. 2017, 501, 294–303. [Google Scholar] [CrossRef]
- Maisch, T. Resistance in antimicrobial photodynamic inactivation of bacteria. Photochem. Photobiol. Sci. 2015, 14, 1518–1526. [Google Scholar] [CrossRef]
- Jindal, A.K.; Pandya, K.; Khan, I.D. Antimicrobial resistance: A public health challenge. Med. J. Armed Forces India 2015, 71, 178–181. [Google Scholar] [CrossRef]
- Bierer, D.E.; Gerber, R.E.; Jolad, S.D.; Ubillas, R.P.; Randle, J.; Nauka, E.; Latour, J.; Dener, J.M.; Fort, D.M.; Kuo, J.E.; et al. Isolation, structure elucidation, and synthesis of irlbacholine, 1, 22-Bis [[[2-(trimethylammonium) ethoxy] phosphinyl] oxy] docosane: A novel antifungal plant metabolite from Irlbachia alata and Anthocleista djalonensis. J. Org. Chem. 1995, 60, 7022–7026. [Google Scholar] [CrossRef]
- Lu, Q.; Ubillas, R.P.; Zhou, Y.; Dubenko, L.G.; Dener, J.M.; Litvak, J.; Phuan, P.-W.; Flores, M.; Ye, Z.; Gerber, E.; et al. Synthetic analogues of irlbacholine: A novel antifungal plant metabolite isolated from Irlbachia alata. J. Nat. Prod. 1999, 62, 824–828. [Google Scholar] [CrossRef] [PubMed]
- McCaig, L.F.; Mc Donald, L.C.; Mandal, S.; Jernigan, D.B. Staphylococcus aureus-associated skin and soft tissue infections in ambulatory care. Emerg. Infect. Dis. 2006, 12, 1715–1723. [Google Scholar] [CrossRef] [PubMed]
- Hendriksen, C.F. Replacement, reduction and refinement alternatives to animal use in vaccine potency measurement. Expert Rev. Vaccines 2009, 8, 313–322. [Google Scholar] [CrossRef] [PubMed]
- Nowak-Sliwinska, P.; Segura, T.; Iruela-Arispe, M.L. The chicken chorioallantoic membrane model in biology, medicine and bioengineering. Angiogenesis 2014, 17, 779–804. [Google Scholar] [CrossRef] [PubMed]
- Steiling, W.; Bracher, M.; Courtellemont, P.; De Silva, O. The HET–CAM, a useful in vitro assay for assessing the eye irritation properties of cosmetic formulations and ingredients. Toxicol. In Vitro 1999, 13, 375–384. [Google Scholar] [CrossRef]
- Spielmann, H.; Kalweit, S.; Liebsch, M.; Wirnsberger, T.; Gerner, I.; Bertram-Neis, E.; Steiling, W. Validation study of alternatives to the Draize eye irritation test in Germany: Cytotoxicity testing and HET-CAM test with 136 industrial chemicals. Toxicol. In Vitro 1993, 7, 505–510. [Google Scholar] [CrossRef]
- Luepke, N.P. Hen’s egg chorioallantoic membrane test for irritation potential. Food Chem. Toxicol. 1985, 23, 287–291. [Google Scholar] [CrossRef]

| Bolalipid | Sample | Non-Irradiated [mm] | Irradiated [mm] |
|---|---|---|---|
| PC-C32-PC | aerogel | 4.5 | 4.7 |
| aerogel containing MB | 5.3 | 13.7 | |
| Me2PE-C32-Me2PE | aerogel | 4.0 | 4.7 |
| aerogel containing MB | 6.7 | 15.3 |
© 2019 by the authors. Licensee MDPI, Basel, Switzerland. This article is an open access article distributed under the terms and conditions of the Creative Commons Attribution (CC BY) license (http://creativecommons.org/licenses/by/4.0/).
Share and Cite
Goergen, N.; Wojcik, M.; Drescher, S.; Pinnapireddy, S.R.; Brüßler, J.; Bakowsky, U.; Jedelská, J. The Use of Artificial Gel Forming Bolalipids as Novel Formulations in Antimicrobial and Antifungal Therapy. Pharmaceutics 2019, 11, 307. https://doi.org/10.3390/pharmaceutics11070307
Goergen N, Wojcik M, Drescher S, Pinnapireddy SR, Brüßler J, Bakowsky U, Jedelská J. The Use of Artificial Gel Forming Bolalipids as Novel Formulations in Antimicrobial and Antifungal Therapy. Pharmaceutics. 2019; 11(7):307. https://doi.org/10.3390/pharmaceutics11070307
Chicago/Turabian StyleGoergen, Nathalie, Matthias Wojcik, Simon Drescher, Shashank Reddy Pinnapireddy, Jana Brüßler, Udo Bakowsky, and Jarmila Jedelská. 2019. "The Use of Artificial Gel Forming Bolalipids as Novel Formulations in Antimicrobial and Antifungal Therapy" Pharmaceutics 11, no. 7: 307. https://doi.org/10.3390/pharmaceutics11070307
APA StyleGoergen, N., Wojcik, M., Drescher, S., Pinnapireddy, S. R., Brüßler, J., Bakowsky, U., & Jedelská, J. (2019). The Use of Artificial Gel Forming Bolalipids as Novel Formulations in Antimicrobial and Antifungal Therapy. Pharmaceutics, 11(7), 307. https://doi.org/10.3390/pharmaceutics11070307

